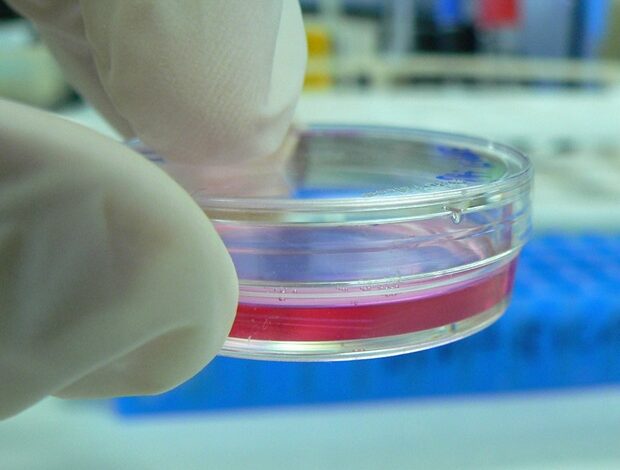

Inženýři vytvářejí návrhářské bioboty pomocí lidských plicních buněk
V Laboratoři Ren Carnegie Mellon University probíhá zbrusu nový inženýrský přístup k vytváření biologických robotů „návrhářů“ pomocí lidských plicních buněk. Tito roboti pro mikroskopické roboty, označované jako agreboty, mohou jednoho dne schopni procházet komplexní prostředí těla, aby poskytovali požadované terapeutické nebo mechanické intervence, jakmile je dosaženo většího kontroly nad jejich vzory motility. V novém výzkumu zveřejněném v Pokroky vědySkupina poskytuje novou platformu pro tkáňové inženýrství, která je schopna dosáhnout přizpůsobitelné motility v aggrebotech aktivně ovládáním jejich strukturálních parametrů.
Biobots jsou mikroskopické, umělé biologické stroje schopné autonomního pohybu a programovatelnosti provádět specifické úkoly nebo chování. Dříve byla povolení pohyblivosti Biobots soustředěna kolem s použitím svalových vláken, která jim umožňují pohybovat se stahováním a relaxací jako skutečné svaly.
Nový, alternativní mechanismus ovládání lze nalézt pomocí cilií, nanoskopických, vlasů podobných organických vrtulech, které neustále pohybují tekutiny v těle (jako v plicích) a pomáhají některým vodním tvorům, jako jsou jako například Paramecium nebo hřebeny, plavat. Spolehlivý způsob, jak ovládat přesný tvar a strukturu Biobota poháněného cilií (zkrátka ciliabot), a tím je jeho výsledek motility, se však ukázalo jako obtížné přijít.
Laboratoř REN propagovala novou strategii modulární sestavy pro ciliaboty pomocí prostorově kontrolované agregace tkáňových sféroidů, které jejich laboratorní inženýři z plicních kmenových buněk. Pomocí strategie mohou tyto agregované ciliaboty (aggreboty) zahrnovat sféroidy kmenových buněk nesoucích a a Genetická mutace To způsobuje cilii v konkrétních regionech nefunkční a immotilní.
Dhruv Bhattaram, první autor dokumentu a biomedicínského inženýrství Ph.D. Student přirovnal proces odebrání vesla na vybraných místech na veslovném člunu při pádlování.
Posouváme dopředu alternativní metodu napájení tkání biobot s našimi agreboty. Prostřednictvím procesu spojování společných sféroidů do různých tvarů, spolu se začleněním nefunkčních sféroidů, můžeme přesně ovládat umístění a hojnost vrtulí řasy na povrchu tkáně, aby poprvé nasměrovaly chování ciliabot. Jedná se o klíčový krok vpřed, do kterého můžeme my a ostatní investovat čas pro produktivní výsledky. “
Dhruv Bhattaram, první autor příspěvku
„Přístup Aggrebots přidává těmto typům biobotů a biohybridních robotů novou dimenzi designu,“ dodala Victoria Webster-Wood, docentka strojního inženýrství. „Schopnost kombinovat různé ciliated a neciliované prvky modulární umožní budoucím vědcům vytvářet bioboty se specifickými vzory mobility s mobilitou. Protože jsou agreboty vyráběny výhradně z biologických materiálů, jsou přirozeně biologicky rozložitelné a biokompatibilní, což může v budoucnu umožnit jejich přímé použití v budoucnosti.“
Vzhledem k tomu, že laboratoř Ren nadále staví na platformě, uznávají, že technologie by mohla prospívat široké škále publika, včetně těch v komunitě Biorobotics, klinických lékařů a lékařských vědců, kteří studují, jak cilia pracuje na onemocněních, jako je primární ciliární dyskineze nebo v silném, vysoce viskozitním slizním cystické fibróze. Zejména ciliaboty mohou být vyrobeny z vlastních buněk pacienta, které by mohly být použity k vytvoření personalizovaných terapeutických dodávkových vozidel, aniž by se riskovalo imunitní odmítnutí.
Motility záleží, protože tělo je složité prostředí. Buněčné dodávání terapeutik má velký potenciál, ale bez řádného pohonného mechanismu se buňky mohou snadno uvíznout. Položili jsme cestu, kterou mohou lidé použít k ovládání motility ciliabot. Od pomoci nám porozumět zdraví dopadů rizik životního prostředí k usnadnění terapeutického porodu in vivo mají ciliaboty rozsah potenciálních využití a je vzrušující být součástí jejich vývoje. ““
XI (Charlie) Ren, docent biomedicínského inženýrství
Zdroj:
Reference časopisu:
Bhattaram, D., et al. (2025). Aggrebots: Konfigurace ciliabotů prostřednictvím řízené modulární agregace tkáně. Pokroky vědy. doi.org/10.1126/sciadv.adx4176




